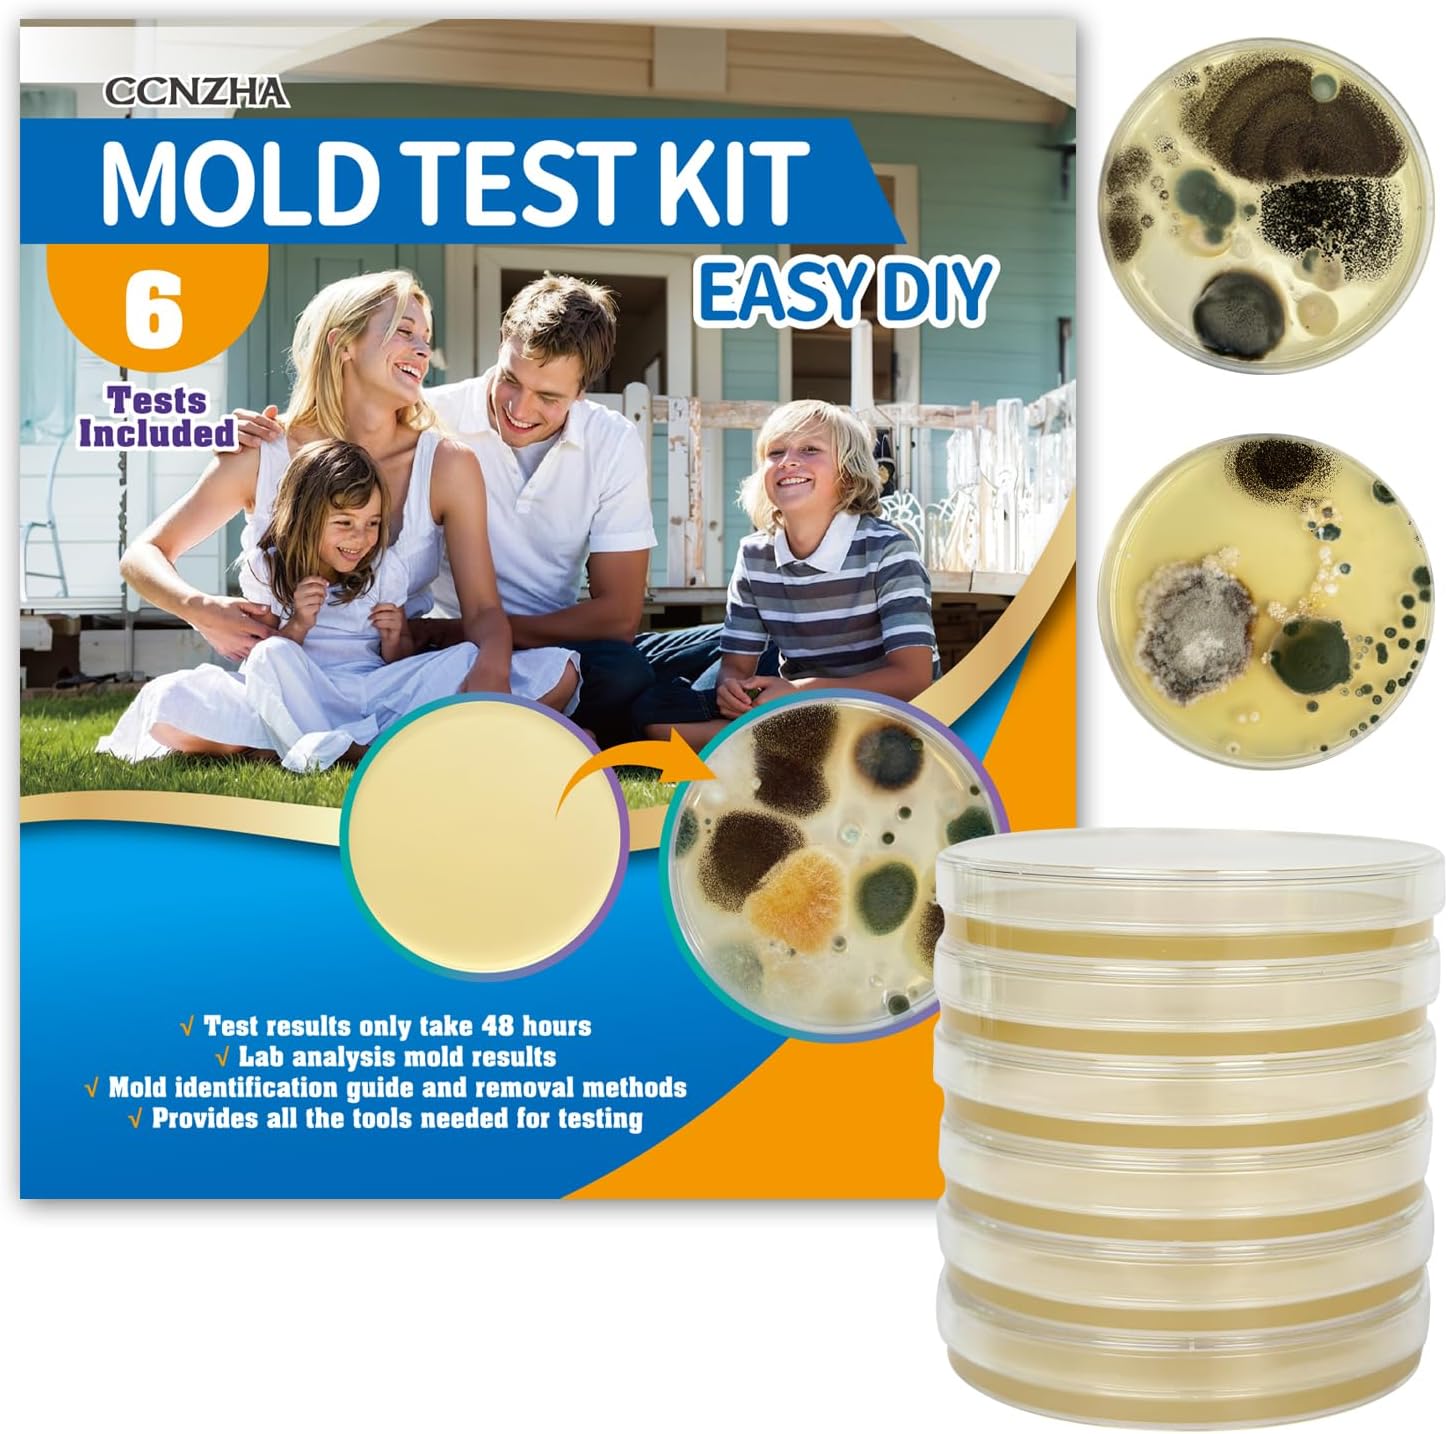
Mold Test Kit for Home -DIY Mold Testing Kit with 6 Individual Tests-Black Mold Detector-Indoor Air Quality Tester-Mold Identification Guide-Free Lab Analysis-Fast and Reliable Mold Detector at Home

Buy anything from 5,000+ international stores. One checkout price. No surprise fees. Join 2M+ shoppers on Desertcart.
Desertcart purchases this item on your behalf and handles shipping, customs, and support to Colombia.
🏠 Detect Mold Before It Detects You – Stay Safe, Stay Ahead!
This Mold Test Kit offers 6 individual test plates and all necessary tools to identify household molds quickly and safely. With results in 48 hours and free expert lab analysis, it empowers you to monitor indoor air quality and protect your home from toxic molds like black mold—all without expensive lab fees or complicated procedures.







| ASIN | B0DFBVNZV8 |
| Customer Reviews | 4.4 4.4 out of 5 stars (866) |
| Date First Available | 19 October 2024 |
| Item Weight | 381 g |
| Manufacturer reference | CCNZHA-6 |
| Package Dimensions | 13.79 x 12.29 x 11.2 cm; 381 g |
M**A
Must buy if you have unexplained allergies in your home
Very easy to use, and the reports shared by the company are very useful. This kit has helped me identify where and why I was reacting so poorly to my environment
J**E
Great customer service
I bought these kits last month. Sent over the results to the email provided and they were very quick in sending back a report of the findings
M**S
Instructions were very clear, and the team responded quickly and thoroughly to all of my questions about the mold test results. I really appreciated how easy they made the entire process...from following the sampling instructions to understanding the final report. I would definitely recommend this company to anyone who needs reliable mold testing and clear guidance on interpreting the results. And great price for it all too!
I**N
Excelente producto. Muy fácil de usar. Tiene instrucciones para que puedas ver que tipo de mold tienes y si no está seguro puedes enviar una foto al laboratorio, a mi me contestaron en unas horas. Si lo volvería a comprar
A**R
Following the easy to follow instructions, the testing performed well. I am grateful that the documentation provided showed and explained the different kinds of molds, very informative. I also sent pictures to their lab to confirm what I was seeing. Dispote the warning it could take up the 3 weeks to get a report, it was done the same day. The report was easy to follow. I appreciated the possible effects on our health for each type of mold. All on all, I would use this product from this vendor again.
J**N
This is a great product to use. This mold test kit is easy to prepare, affordable, and it comes with a little notebook that visually represents what kind of mold is in the petri dish and how to get rid of it. Additionally, you can also contact the lab (contact information is in the little notebook) to get a professional look at whether or not you have mold in your house. Overall, this product is great and could save you from a bunch of health related issues.
A**R
Great product. Highly recommended!
Trustpilot
Hace 1 mes
Hace 1 mes